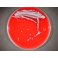
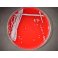
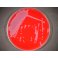

Dealer wanted
Comprehensive Selection of Supplements for Dehydrated Culture Media - New! Specialized Supplements for Optimal Microbiological Media Performance Now available for use with our MicroMedia-branded dehydrated media or as standalone additives – delivering enhanced selectivity, enrichment, and reliability for your lab.
|
Full automatic can lid feeder at Coca-Cola factory - New Unit-Fine Fully Automatic Can Lid Feeder Installed at Coca-Cola Plant |
B20 can lid feeder at Bakalar Brewery -
Unit-Fine Installs First B20 Can Lid Feeder with Round Magazine Loader at Bakalář Brewery
Products
ISO-Sensitest Agar MM0085
Description
Use and description of ISO-Sensitest agar :
Field : Clinical microbiology
Special field : Semisynthetic media - for antibiotic sensitivity testing
Organisms : Aerobe
Application :
- Media for sensitivity testing
Substantial composition : low thymine and thymidine content , constant composition
Special field of application :
- trimethropin and sulfonamides sensitivity testing
Downloads
Newsletter
In this newsletter publication we highlight our activities, featuring briefly past and upcoming events, new publications, as well as major news!
MicroMedia Trading House
Address: 10130 Tallin Kiriku Tn 6, Hungary
Phone: +36306013634, Fax: ,
Support: support@micromediatradinghouse.com
Address: 10130 Tallin Kiriku Tn 6, Hungary
Phone: +36306013634, Fax: ,
Support: support@micromediatradinghouse.com